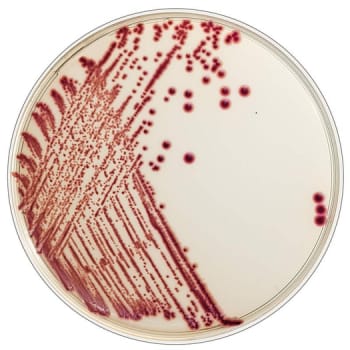
Flexicult, Chrom agar Flexicult ID

Køb ID Flexicult™ kromogen agarplade online hos Mediq.
ID Flexicult™ anvendes til identifikation og kvantificering af urinvejspatogene bakterier, hvilket understøtter diagnostik af urinvejsinfektioner. Denne agarplade er særligt udviklet til mikrobiologisk diagnostik og sikrer hurtige og præcise resultater.
Værd at vide om ID Flexicult™:
-
Kromogen agarplade til identifikation af bakterier i urinprøver
-
Mulighed for kvantificering af patogene bakterier
-
Opbevares mørkt og på køl (2-8°C)
-
Sidste anvendelsesdato fremgår af bunden af pladen
-
Brugte plader skal bortskaffes som smittefarligt affald
Mere information
ID Flexicult™ er udviklet til hurtig og præcis påvisning af urinvejsinfektioner. Pladen indeholder kromogene substrater, der gør det muligt at identificere bakteriearter baseret på farvereaktioner. Denne type agarplade kan også anvendes til kvantificering af bakterievækst, hvilket er afgørende for at vurdere infektionsgraden.
Sådan anvender du ID Flexicult™:
Pladen podes med en urinprøve og inkuberes i henhold til laboratoriets protokoller. Efter endt inkubation vurderes bakterievækst ud fra farvereaktioner og kolonitælling. Resultaterne anvendes til diagnostik og behandlingsvejledning.
Information til sundhedsfaglige personer
ID Flexicult™ anvendes i mikrobiologiske laboratorier og kliniske miljøer til identifikation og kvantificering af urinvejspatogene bakterier. Den kromogene agarplade giver hurtige og pålidelige resultater, der understøtter diagnosticering og behandling af urinvejsinfektioner.
Kliniske forhold og anvendelse:
-
Kromogen agarplade til mikrobiologisk diagnostik
-
Bruges til identifikation og kvantificering af urinvejspatogene bakterier
-
Skal opbevares mørkt og på køl ved 2-8°C
-
Skal håndteres som smittefarligt affald efter brug